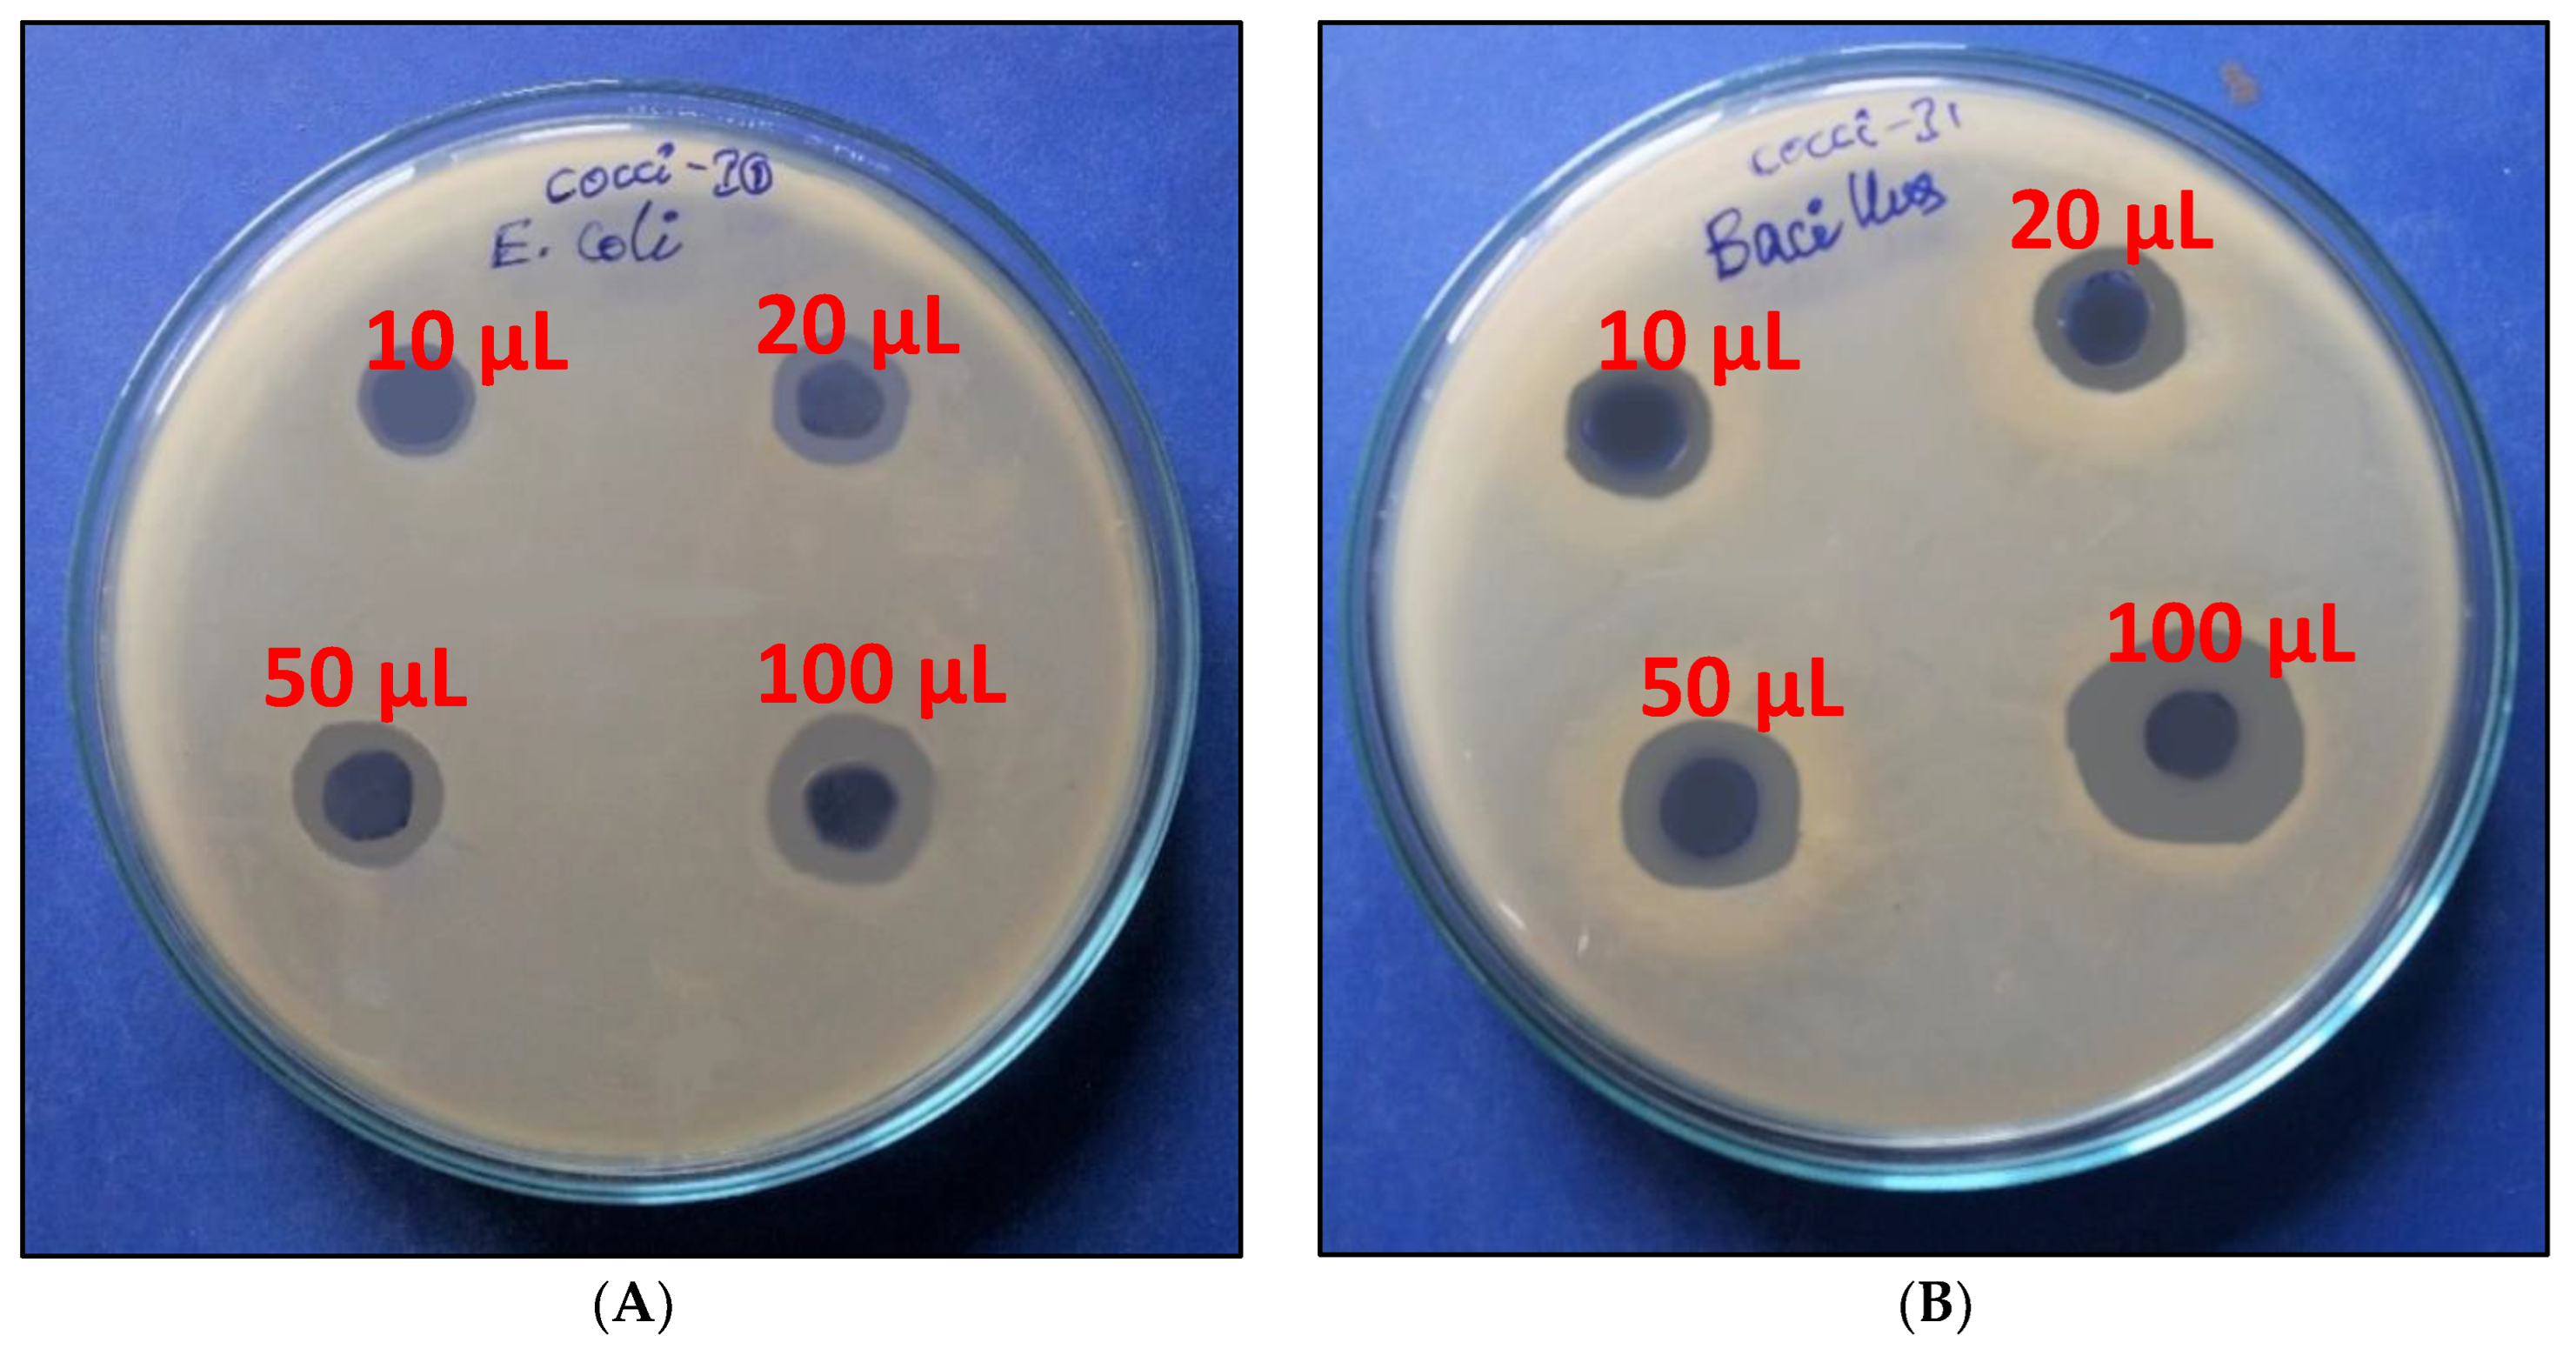

Isolation and Characterization of Pediococcus sp. HLV1 from Fermented Idly Batter
Abstract
:1. Introduction
2. Materials and Methods
2.1. Isolation of Lactic Acid Bacteria
2.2. Morphological and Physiological Characterization
Scanning Electron Microscope (SEM)
2.3. Molecular Identification
2.4. Optimization of Fermentation Factors
2.5. Antimicrobial Activity
2.6. Lactic Acid Production from Mango Peel
2.7. Analysis
2.8. Statistical Analysis
3. Results and Discussion
3.1. Molecular Identification
3.2. Optimization Studies
3.2.1. Carbon Source
3.2.2. Nitrogen Source
3.2.3. pH
3.2.4. Temperature
3.3. Antibacterial Activity
3.4. Lactic Acid Production from Mango Industrial Waste
4. Conclusions
Author Contributions
Funding
Institutional Review Board Statement
Informed Consent Statement
Data Availability Statement
Conflicts of Interest
References
- Available online: http://www.grandviewresearch.com/industryanalysis/lactic-acid-and-poly-lactic-acid-market (accessed on 10 December 2021).
- Ghaffar, T.; Irshad, M.; Anwar, Z.; Aqil, T.; Zulifqar, Z.; Tariq, A.; Kamran, M.; Ehsan, N.; Mehmood, S. Recent trends in lactic acid biotechnology: A brief review on production to purification. J. Radiat. Res. Appl. Sci. 2014, 7, 222–229. [Google Scholar] [CrossRef]
- Fevria, R.; Hartanto, I. Isolation and characterization of lactic acid bacteria (Lactobacillus sp.) from strawberry (Fragaria vesca). Int. J. Phys Conf. Ser. 2009, 1371, 012086. [Google Scholar] [CrossRef] [Green Version]
- Cui, F.; Li, Y.; Wan, C. Lactic acid production from corn stover using mixed cultures of Lactobacillus rhamnosus and Lacto-bacillus brevis. Biores. Technol. 2011, 102, 1831–1836. [Google Scholar] [CrossRef] [PubMed]
- Nancib, A.; Nancib, N.; Boudrant, J. Production of lactic acid from date juice extract with free cells of single and mixed cultures of Lactobacillus casei and Lactococcus lactis. World J. Microbiol. Biotechnol. 2009, 25, 1423–1429. [Google Scholar] [CrossRef]
- Agaliya, P.J.; Jeevaratnam, K. Molecular characterization of lactobacilli isolated from fermented idli batter. Braz. J. Microbiol. 2013, 44, 1199–1206. [Google Scholar] [CrossRef] [PubMed] [Green Version]
- Sathe, G.B.; Mandal, S. Fermented products of India and its implication: A review. Asian J. Dairy Food Res. 2016, 35, 1–9. [Google Scholar] [CrossRef]
- Abdel-Rahman, M.A.; Tashiro, Y.; Sonomoto, K. Recent advances in lactic acid production by microbial fermentation processes. Biotechnol. Adv. 2013, 31, 877–902. [Google Scholar] [CrossRef]
- Sakdaronnarong, C.; Srimarut, N.; Lucknakhul, N.; Na-songkla, N.; Jonglertjunya, W. Two-step acid and alkaline methanolysis/alkaline peroxide fractionation of sugarcane bagasse and rice straw for production of polylactic acid precursor. Bio-Chem. Eng. J. 2014, 85, 49–62. [Google Scholar]
- Nancib, N.; Nancib, A.; Boudjelal, A.; Benslimane, C.; Blanchard, F.; Boudrant, J. The effect of supplementation by different nitrogen sources on the production of lactic acid from date juice by Lactobacillus casei subsp. rhamnosus. Bioresour. Technol. 2001, 78, 149–153. [Google Scholar] [CrossRef]
- Neu, A.-K.; Pleissner, D.; Mehlmann, K.; Schneider, R.; Puerta-Quintero, G.I.; Venus, J. Fermentative utilization of coffee mucilage using Bacillus coagulans and investigation of down-stream processing of fermentation broth for optically pure l(+)-lactic acid production. Bioresour. Technol. 2016, 211, 398–405. [Google Scholar] [CrossRef]
- Reddy, L.V.; Reddy, O.V.S.; Wee, Y.J. Production of ethanol from mango (Mangifera indica L.) peel by Saccharomyces cerevisiae CFTRI101. Afr. J. Biotechnol. 2011, 10, 4183–4189. [Google Scholar]
- Avula, S.V.; Reddy, S.; Reddy, L.V. The Feasibility of Mango (Mangifera indica L.) Peel as an Alternative Substrate for Butanol Production. BioResources 2015, 10, 4453–4459. [Google Scholar] [CrossRef]
- Jawad, A.H.; Alkarkhi, A.F.; Jason, O.C.; Easa, A.M.; Norulaini, N.N. Production of the lactic acid from mango peel waste—Factorial experiment. J. King Saud Univ. Sci. 2013, 25, 39–45. [Google Scholar] [CrossRef] [Green Version]
- Sreedhara, M.M.; Vijaya, S.R.O. Lactic Acid Production Using Mango Peel: Studies on Lactic Acid Production Using Mango Peel and Its Use in Bio-Film Preparation; LAP Lambert Academic Publishing: Sunnyvale, CA, USA, 2019. [Google Scholar]
- Reddy, L.V.; Sreeveda, A.; Park, I.H.; Wee, Y.J. Isolation and characterization of Clostridia from the feces of wild rabbit and swine for hemicellulosic acetone-butanol-ethanol (ABE) production. BioResources 2019, 14, 5832–5844. [Google Scholar]
- Srihasam, S.; Thyagarajan, K.; Korivi, M.; Lebaka, V.R.; Mallem, S.P.R. Phytogenic Generation of NiO Nanoparticles Using Stevia Leaf Extract and Evaluation of Their In-Vitro Antioxidant and Antimicrobial Properties. Biomolecules 2020, 10, 89. [Google Scholar] [CrossRef] [Green Version]
- Miller, G.L. Use of Dinitrosalicylic Acid Reagent for Determination of Reducing Sugar. Anal. Chem. 1954, 31, 426–428. [Google Scholar] [CrossRef]
- Pal, V.; Jamuna, M.; Jeevaratnam, K. Isolation and characterization of bacteriocin producing lactic acid bacteria from a south Indian special dosa (Appam) batter. J. Cult. Collect. 2005, 4, 53–60. [Google Scholar]
- Ruiz Rodriguez, L.G.; Mohamed, F.; Bleckwedel, J.; Medina, R.; De Vuyst, L.; Hebert, E.M.; Mozzi, F. Diversity and functional properties of lactic acid bacteria isolated from wild fruits and flowers present in Northern Argentina. Front. Microbiol. 2019, 10, 1091. [Google Scholar] [CrossRef]
- Patil, M.M.; Pal, A.; Anand, T.; Ramana, K.V. Isolation and characterization of lactic acid bacteria from curd and cucumber. Indian J. Biotechnol. 2010, 9, 166–172. [Google Scholar]
- Olasupo, N.A.; Schillinger, U.; Holzapfel, W.H. Studies on some technological properties of predominant lactic acid bacteria isolated from nigerian fermented foods. Food Biotechnol. 2001, 15, 157–167. [Google Scholar] [CrossRef]
- Garvie, E.I. Genus Pediococcus. In Bergey’s Manual of Systematic Bacteriology; Sneath, P.H.A., Mair, N.S., Sharpe, M.E., Holt, J.G., Eds.; The Williams & Wilkins Co.: Baltimore, MD, USA, 1986; Volume 2, pp. 1075–1079. [Google Scholar]
- NCBI Resources Genbank. Available online: http://www.ncbi.nlm.nih.gov/genbank/ (accessed on 19 September 2012).
- Leh, M.B.; Charles, M. Lactic acid production by batch fermentation of whey permeate: A mathematical model. J. Ind. Microbiol. Biotechnol. 1989, 4, 65–70. [Google Scholar] [CrossRef]
- Nancib, N.; Nancib, A.; Boudjelal, A.; Benslimane, C.; Blanchard, F.; Boudrant, J. Joint effect of nitrogen sources and B vitamin supplementation of date juice on lactic acid production by Lactobacillus casei subsp. rhamnosus. Bioresour. Technol. 2005, 96, 63–67. [Google Scholar] [CrossRef] [PubMed]
- Cheng, P.; Muller, S.; Bajpai, R.; Lannotti, E.L. Lactic acid production from enzyme thinned corn starch using Lactobacillus amylovorus. J. Ind. Microbiol. 1991, 7, 27–34. [Google Scholar] [CrossRef]
- Abdel-Rahman, M.A.; Sonomoto, K. Opportunities to overcome the current limitations and challenges for efficient microbial production of optically pure lactic acid. J. Biotechnol. 2016, 236, 176–192. [Google Scholar] [CrossRef] [PubMed]
- Åkerberg, C.; Hofvendahl, K.; Zacchi, G.; Hahn-Hägerdal, B. Modelling the influence of pH, temperature, glucose and lactic acid concentrations on the kinetics of lactic acid production by Lactococcus lactis ssp. lactis ATCC 19435 in whole-wheat flour. Appl. Microbiol. Biotechnol. 1998, 49, 682–690. [Google Scholar] [CrossRef]
- Calabia, B.P.; Tokiwa, Y.; Aiba, S. Fermentative production of l-(+)-lactic acid by an alkaliphilic marine microorganism. Biotechnol. Lett. 2011, 33, 1429–1433. [Google Scholar] [CrossRef]
- Ding, S.; Tan, T. l-lactic acid production by Lactobacillus casei fermentation using different fed-batch feeding strategies. Process Biochem. 2006, 41, 1451–1454. [Google Scholar] [CrossRef]
- Alam, M.T.; Mahato, A.K.; Kumari, L.; Singh, R.S. Fermentative study on optimization of lactic acid production from cane sugar by Lactobacillus spp. Eur. J. Molec. Clin. Med. 2021, 8, 712–723. [Google Scholar]
- Nze, U.C.; Beeman, M.G.; Lambert, C.J.; Salih, G.; Gale, B.K.; Sant, H.J. Hydrodynamic cavitation for the rapid separation and electrochemical detection of Cryptosporidium parvum and Escherichia coli O157:H7 in ground beef. Biosens. Bioelectron. 2019, 135, 137–144. [Google Scholar] [CrossRef] [Green Version]
- Orsi, R.H.; Wiedmann, M. Characteristics and distribution of Listeria spp., including Listeria species newly described since 2009. Appl. Microbiol. Biotechnol. 2016, 100, 5273–5287. [Google Scholar] [CrossRef] [Green Version]
- Lele, V.; Zelvyte, R.; Monkeviciene, I.; Kantautaite, J.; Stankevicius, R.; Ruzauskas, M.; Sederevicius, A.; Antanaitis, R.; Bartkiene, E. Milk production and ruminal parameters of dairy cows fed diets containing Lactobacillus sakei KTU05-6 and Pediococcus pentosaceus BaltBio02. Pol. J. Vet. Sci. 2019, 22, 327–335. [Google Scholar] [PubMed]
- Nanasombat, S.; Treebavonkusol, P.; Kittisrisopit, S.; Jaichalad, T.; Phunpruch, S.; Kootmas, A.; Nualsri, I. Lactic acid bacteria isolated from raw and fermented pork products: Identification and characterization of catalase-producing Pediococcus pentosaceus. Food Sci. Biotechnol. 2017, 26, 173–179. [Google Scholar] [CrossRef] [PubMed]
- Yu, S.; Zhou, C.; Zhang, T.; Jiang, B.; Mu, W. Short communication: 3-phenyllactic acid production in milk by Pediococcus pentosaceus SK25 during laboratory fermentation process. J. Dairy Sci. 2015, 98, 813–817. [Google Scholar] [CrossRef] [Green Version]
- Reddy, L.V.; Kim, Y.-M.; Yun, J.-S.; Ryu, H.-W.; Wee, Y.-J. l-Lactic acid production by combined utilization of agricultural bioresources as renewable and economical substrates through batch and repeated-batch fermentation of Enterococcus faecalis RKY1. Bioresour. Technol. 2016, 209, 187–194. [Google Scholar] [CrossRef]

| Tests | Isolate 1 | Isolate 2 | Isolate 3 | Isolate 4 | Isolate 5 | Isolate 6 |
|---|---|---|---|---|---|---|
| Cell morphology | Cocci | Cocci | Cocci | Cocci | Cocci | Cocci |
| Gram test | + | + | + | + | + | + |
| Motility | - | - | - | - | - | - |
| Catalase | - | - | - | - | - | - |
| Biochemical characteristics | ||||||
| Gelatin | - | - | - | - | - | - |
| Indole | - | - | - | - | - | - |
| Methyl red | + | + | + | + | - | - |
| Vogues–Proskauer | - | - | - | - | - | - |
| Citrate | - | - | - | - | - | - |
| H2S production | - | - | - | - | - | - |
| Glycerol | - | - | - | - | - | - |
| Fermentation of carbohydrates | ||||||
| Glucose | + | + | + | + | + | + |
| Sucrose | + | + | + | + | + | + |
| Fructose | + | + | + | + | + | + |
| Mannose | + | + | + | + | + | + |
| Xylose | + | + | + | + | + | + |
| Arabinose | - | - | - | - | - | - |
| Maltose | - | - | - | - | - | - |
| Galactose | + | + | + | + | + | + |
| Sorbitol | - | - | - | - | - | - |
| CMC | - | - | - | - | - | - |
Publisher’s Note: MDPI stays neutral with regard to jurisdictional claims in published maps and institutional affiliations. |
© 2022 by the authors. Licensee MDPI, Basel, Switzerland. This article is an open access article distributed under the terms and conditions of the Creative Commons Attribution (CC BY) license (https://creativecommons.org/licenses/by/4.0/).
Share and Cite
Katepogu, H.; Wee, Y.-J.; Almaary, K.S.; Elbadawi, Y.B.; Gobinath, R.; Chinni, S.V.; Lebaka, V.R. Isolation and Characterization of Pediococcus sp. HLV1 from Fermented Idly Batter. Fermentation 2022, 8, 61. https://doi.org/10.3390/fermentation8020061
Katepogu H, Wee Y-J, Almaary KS, Elbadawi YB, Gobinath R, Chinni SV, Lebaka VR. Isolation and Characterization of Pediococcus sp. HLV1 from Fermented Idly Batter. Fermentation. 2022; 8(2):61. https://doi.org/10.3390/fermentation8020061
Chicago/Turabian StyleKatepogu, Harika, Young-Jung Wee, Khalid S. Almaary, Yahya B. Elbadawi, Ramachawolran Gobinath, Suresh V. Chinni, and Veeranjaneya Reddy Lebaka. 2022. "Isolation and Characterization of Pediococcus sp. HLV1 from Fermented Idly Batter" Fermentation 8, no. 2: 61. https://doi.org/10.3390/fermentation8020061
APA StyleKatepogu, H., Wee, Y.-J., Almaary, K. S., Elbadawi, Y. B., Gobinath, R., Chinni, S. V., & Lebaka, V. R. (2022). Isolation and Characterization of Pediococcus sp. HLV1 from Fermented Idly Batter. Fermentation, 8(2), 61. https://doi.org/10.3390/fermentation8020061

